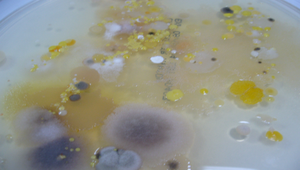

:::
細菌培養照片
資訊
領域:語文領域-國語文
學習階段:國小3-4年級(二)
素材
創用CC 姓名標示 3.0 台灣
2011-11-15
教學資源檔案連結
084727_1950_20091130211747.jpg (513.54KB)
資源評論或心得分享
相關資源